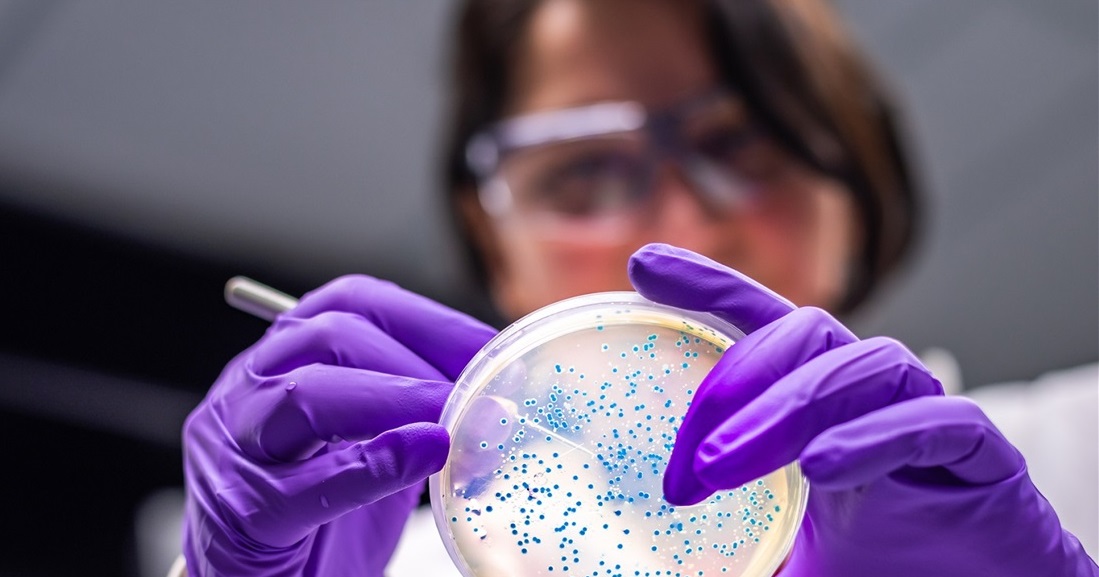

تم سحبها بالكامل من أسواق هذه الدولة.. فاكهة تسبب عدوى السالمونيلا!
حثت مراكز السيطرة على الأمراض والوقاية في الولايات المتحدة المواطنين، على تجنب تناول بعض منتجات الشمام وسط تفشي عدوى السالمونيلا التي أدت إلى وفاة شخصين على الأقل.
وقال مركز السيطرة على الأمراض (سي دي سي)، إنه أصيب ما لا يقل عن 117 شخصًا في 34 ولاية أميركية بالمرض بعد تناول الشمام منذ منتصف تشرين الأول، ومن المرجح أن يكون العدد أعلى من ذلك بكثير.
وتم نقل ما لا يقل عن 61 شخصًا إلى المستشفى وتوفي اثنان في مينيسوتا، وقالت الوكالة إنها تشعر بقلق خاص بشأن تفشي المرض لأن الإصابات كانت شديدة وحدث بعضها في مرافق الرعاية الصحية، مشيرة إلى إن 14 بالغا في مرافق الرعاية وسبعة أطفال أصيبوا بالمرض.
وتم سحب الشمام الكامل الذي يحمل العلامة التجارية Malichita أو Rudy في الشهر الفائت، وفقًا لإدارة الغذاء والدواء.
وقد تحتوي حبات الشمام هذه على ملصقات مكتوب عليها "Malichita" أو "Rudy" أو "4050" أو "Product of Mexico/produit du Mexique"، وفقًا لمركز السيطرة على الأمراض.
وتم بيع الشمام المقطع مسبقًا في متاجر عديدة مثل "ألدي" و"والمارت" في بعض الولايات.
وتوصي مراكز السيطرة على الأمراض الأشخاص بعدم تناول الشمام المقطع مسبقًا إذا لم يتمكنوا من معرفة ما إذا كان يأتي من علامة تجارية تم سحبها.
وتحقق وكالة الصحة العامة الكندية أيضًا في تفشي مرض السالمونيلا المرتبط بمنتجات الشمام، مع ما لا يقل عن 63 حالة، وفق صحيفة "وول ستريت جورنال".
وتم نقل 17 شخصا إلى المستشفى، وتوفي شخص واحد، بحسب الوكالة الكندية.
وهناك حوالي 1.35 مليون إصابة بالسالمونيلا في الولايات المتحدة كل عام، وفقًا لمركز السيطرة على الأمراض.
وقد يعاني المصابون بالسالمونيلا من الحمى والإسهال وتشنجات المعدة، وتبدأ الأعراض ما بين ست ساعات إلى ستة أيام بعد إصابة الشخص.